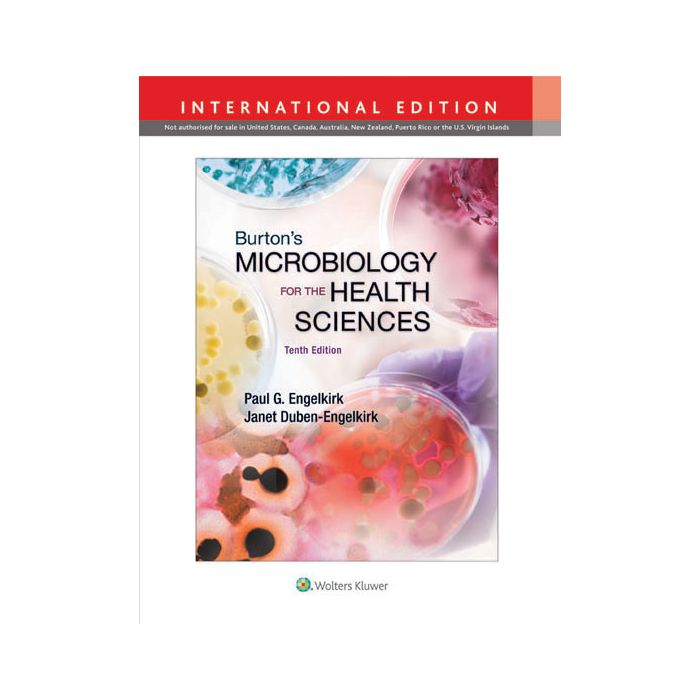
Burton's Microbiology for the Health Sciences, 10ed. - Engelkirk Paul - LIPPINCOTT Williams and Wilkins - 9781451186345 Burton's Microbiology for the Health Sciences, 10ed. - Engelkirk Paul - LIPPINCOTT Williams and Wilkins - 9781451186345

Burton's Microbiology for the Health Sciences, 10ed. [Engelkirk - LIPPINCOTT Williams and Wilkins]
calcActive())">
- ISBN/EAN
- 9781451186345
- Editore
- LIPPINCOTT Williams and Wilkins
- Formato
- Brossura
- Anno
- 2014
- Edizione
- 10
- Pagine
- 496
Disponibile
51,00 €
Written in a straightforward and engaging style, this premier textbook provides students with the foundation in microbiology that they need to perform their day-to-day duties in a safe and knowledgeable manner. Coverage includes the core themes and concepts outlined for an introductory course by the American Society for Microbiology.
Developed for current and future healthcare professionals, the text offers vital coverage of antibiotics and other antimicrobial agents, epidemiology and public health, hospital-acquired infections, infection control, and the ways in which microorganisms cause disease. This comprehensive new edition explores the major viral, bacterial, fungal, and parasitic human diseases, including patient care, and how the body protects itself from pathogens and infectious diseases.
Maggiori Informazioni
| Autore | Engelkirk Paul |
|---|---|
| Editore | LIPPINCOTT Williams and Wilkins |
| Anno | 2014 |
| Tipologia | Libro |
| Lingua | Inglese |
| Indice | Section I: Introduction to Microbiology Chapter 1 Microbiology—The Science Chapter 2 Observing the Microbial World Section II Introduction to Microbes and Cellular Biology Chapter 3 Cell Structure and Taxonomy Chapter 4 Microbial Diversity Chapter 5 Microbial Diversity Section III Chemical and Genetic Aspects of Microorganisms Chapter 6 The Biochemical Basis of Life Chapter 7 Microbial Physiology and Genetics Section IV Controlling the Growth of Microbes Chapter 8 Controlling Microbial Growth In Vitro Chapter 9 Inhibiting the Growth of Pathogens In Vivo Using Antimicrobial Agents Section V Environmental and Applied Microbiology Chapter 10 Microbial Ecology and Microbial Biotechnology Chapter 11 Epidemiology and Public Health Section VI Microbiology within Healthcare Facilities Chapter 12 Healthcare Epidemiology Chapter 13 Diagnosing Infectious Diseases Section VII Pathogenesis and Host Defense Mechanisms Chapter 14 Pathogenesis of Infectious Diseases Chapter 15 Nonspecific Host Defense Mechanisms Chapter 16 Specific Host Defense Mechanisms: An Introduction to Immunology Section VIII Major Infectious Diseases of Humans Chapter 17 Overview of Human Infectious Diseases Chapter 18 Viral Infections of Humans Chapter 19 Bacterial Infections of Humans Chapter 20 Fungal Infections of Humans Chapter 21 Parasitic Infections of Humans |
Questo libro è anche in:
